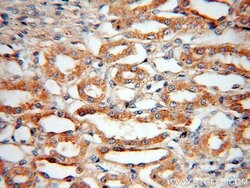
Bif-1 Rabbit anti-Human, Mouse, Rat, Polyclonal, Proteintech 150 &mu;L;

missing translation for 'onlineSavingsMsg'
Learn More
Learn More
Bif-1 Rabbit anti-Human, Mouse, Rat, Polyclonal, Proteintech
Rabbit Polyclonal Antibody
Brand: Proteintech 15422-1-AP-150UL
This item is not returnable.
View return policy
Description
The Bcl-2 family consists of anti-apoptotic (or cell survival) genes, such as Bcl-2, Bcl-XL and pro-apoptotic (or cell death) genes including Bax and BAD. In addition to its anti-apoptotic effect, Bcl-2 also inhibits progression through the cell cycle. Functional interactions between family members as well as binding to other cellular proteins modulate their activities. Bcl-2 family members are important in normal tissue development, homeostasis, and disease states. Bcl-2 prevents cell death by forming heterodimers with Bax and Bad (1). Bax promotes cell death by forming homodimers, which can be blocked by forming heterodimers with Bcl-2 or BCL-XL. Recently, using yeast two-hybrid system Cuddeback et al (product citation 2) have identified a cDNA encoding a 365 amino acid protein, which interacts physically with Bax protein and influences cell life and death. Bif-1 contains a Src homology 3 (SH3) domain in the C-terminus. It does not contain any of the conserved Bcl-2 homology (BH) domains of the Bcl-2 family proteins. Human Bif-1 protein shares 96% and 42% identity at the amino acids level with mouse and C. elegans, respectively. Overexpression of Bif-1 in transfected cell lines promotes Bax conformational change, caspase activation, and apoptotic cell death following growth factor withdrawal. Bif-1 RNA is abundantly expressed in heart, skeletal muscle, kidney, and placenta.Specifications
| Bif-1 | |
| Polyclonal | |
| Unconjugated | |
| SH3GLB1 | |
| Bax interacting factor 1, Bif 1, Bif1, Endophilin B1, SH3GLB1 | |
| Rabbit | |
| Antigen Affinity Chromatography | |
| RUO | |
| 292156, 51100, 54673 | |
| -20°C | |
| Liquid |
| Immunocytochemistry, Immunofluorescence, Immunohistochemistry (Paraffin), Western Blot | |
| 0.29 mg/mL | |
| PBS with 50% glycerol and 0.02% sodium azide; pH 7.3 | |
| Q6AYE2, Q9JK48, Q9Y371 | |
| SH3GLB1 | |
| Bif-1 Fusion Protein Ag7710 | |
| 150 μL | |
| Primary | |
| Human, Mouse, Rat | |
| Antibody | |
| IgG |
Product Content Correction
Your input is important to us. Please complete this form to provide feedback related to the content on this product.
Product Title
Spot an opportunity for improvement?Share a Content Correction